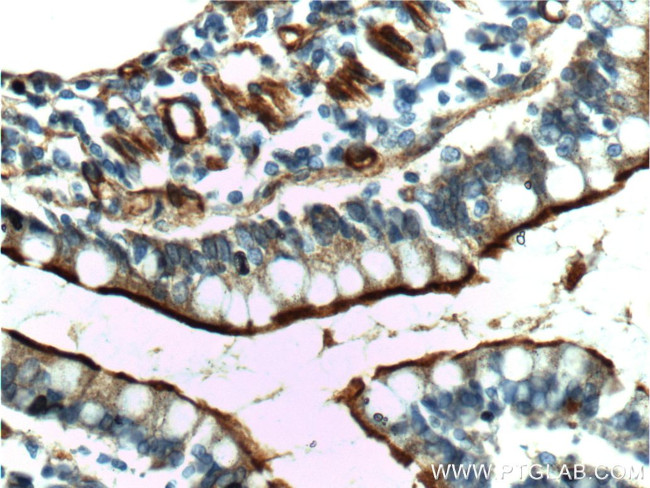
Osteopontin Antibody in Immunohistochemistry (Paraffin) (IHC (P))

Search
Proteintech
Osteopontin Polyclonal Antibody
{{$productOrderCtrl.translations['antibody.pdp.commerceCard.promotion.promotions']}}
{{$productOrderCtrl.translations['antibody.pdp.commerceCard.promotion.viewpromo']}}
{{$productOrderCtrl.translations['antibody.pdp.commerceCard.promotion.promocode']}}: {{promo.promoCode}} {{promo.promoTitle}} {{promo.promoDescription}}. {{$productOrderCtrl.translations['antibody.pdp.commerceCard.promotion.learnmore']}}
产品信息
25715-1-AP
种属反应
已发表种属
宿主/亚型
分类
类型
抗原
偶联物
形式
浓度
规格
纯化类型
保存液
内含物
保存条件
运输条件
产品详细信息
Immunogen sequence: MRIAVICFC LLGITCAIPV KQADSGSSEE KQLYNKYPDA VATWLNPDPS QKQNLLAPQT LPSKSNESHD HMDDMDDEDD DDHVDSQDSI DSNDSDDVDD TDDSHQSDES HHSDESDELV TDFPTDLPAT EVFTPVVPTV DTYDGRGDSV VYGLRSKSKK FRRPDIQYPD ATDEDITSHM ESEELNGAYK AIPVAQDLNA PSDWDSRGKD SYETSQLDDQ SAETHSHKQS RLYKRKANDE SNEHSDVIDS QELSKVSREF HSHEFHSHED MLVVDPKSKE EDKHLKFRIS HELDSASSEV N (1-300 aa encoded by BC007016)
靶标信息
Osteopontin is an arginine-glycine-aspartic acid (RGD)-containing glycoprotein that interacts with integrins and CD44 as major receptors. It is a multifunctional protein involved in bone mineralization, cell adhesion, cell migration, chronic inflammatory disease and transformation. Proteolytic cleavage by thrombin and matrix metalloproteinases close to the integrin-binding Arg-Gly-Asp sequence modulates the function of OPN and its integrin binding properties. Thrombin-cleaved fragments of Osteopontin are overexpressed in malignant glial tumors and provide a molecular niche with survival advantage and provide a novel substrate for plasmin and cathepsin D.
仅用于科研。不用于诊断过程。未经明确授权不得转售。
生物信息学
蛋白别名: 2AR; 44 kDa bone phosphoprotein; Bone sialoprotein 1; Bone sialoprotein 1 (BSPI/BSP1); Calcium oxalate crystal growth inhibitor protein; CALPHA1 fusion; Early T lymphocyte activation 1 (ETA1); early T-lymphocyte activation 1; Early T-lymphocyte activation 1 protein; HGNC:11255; immunoglobulin alpha 1 heavy chain constant region fusion protein; lnc-PKD2-2-3; MGC110940; Minopontin; Nephropontin; OSN-C; OSN-D; Osteopontin; osteopontin-like protein; osteopontin/immunoglobulin alpha 1 heavy chain constant region fusion protein; putative OPN isoform 6; Secreted phosphoprotein 1; secreted phosphoprotein 1 (osteopontin bone sialoprotein I early T lymphocyte activation 1); secreted phosphoprotein 1 (osteopontin, bone sialoprotein I, early T-lymphocyte activation 1); Secreted phosphoprotein 1 (SPP1); Sialoprotein (osteopontin); SPP-1; SPP1/CALPHA1 fusion; unnamed protein product; urinar; Urinary stone protein; Uropontin
基因别名: 2AR; 2b7; Apl-1; BNSP; Bsp; BSPI; Eta; ETA-1; OP; OPN; Opnl; OSP; PSEC0156; Ric; Spp-1; SPP1
UniProt ID: (Human) P10451, (Mouse) P10923, (Rat) P08721
Entrez Gene ID: (Human) 6696, (Mouse) 20750, (Rat) 25353